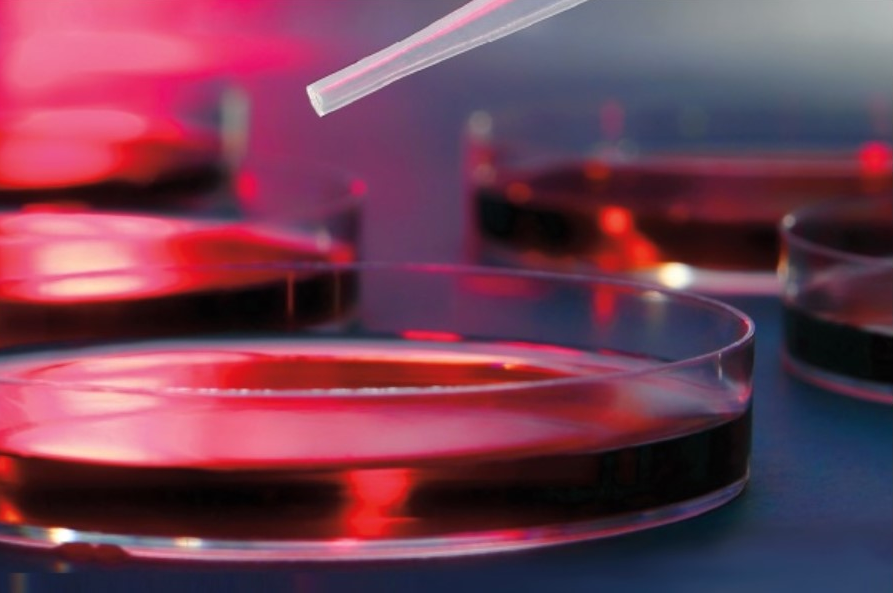

Mayo Clinic 32nd Annual Hematology-Oncology Reviews 2023 (Videos + Slides)
Mayo Clinic’s 32nd Annual Hematology/Oncology Reviews 2023 in Amelia Island, Florida is a comprehensive review of hematology/oncology that focuses on the application of new clinical and research advancements and developments over the preceding year. The most important clinical management questions in hematology/oncology will be addressed in highly interactive sessions. Attendees will leave with up-to-date, practical information that will have immediate clinical application. Attendees are encouraged to bring portable computer devices to view the syllabus on the course website. Attendees are strongly encouraged to download the syllabus from the website prior to the course. Join us at this continuing medical education (CME) conference!
Target Audience
This course is designed for practicing hematologists, medical oncologists, scientists, researchers, nurses, physician assistants, pharmacists and clinical research associates.
Learning Objectives
Upon completion of this activity, participants should be able to:
- List new practice-changing developments in hematology and medical oncology in 2022-2023
- Select the appropriate clinical conditions in oncology and hematology using newly developed 2022 and 2023 treatments
- Identify risks and benefits of new treatments approved by the FDA
- Describe the most important management issues in hematology/oncology and select the best treatments based on current evidence
Course Details:Â https://ce.mayo.edu/hematology-and-oncology/content/32nd-annual-mayo-clinic-hematologyoncology-reviews-2023